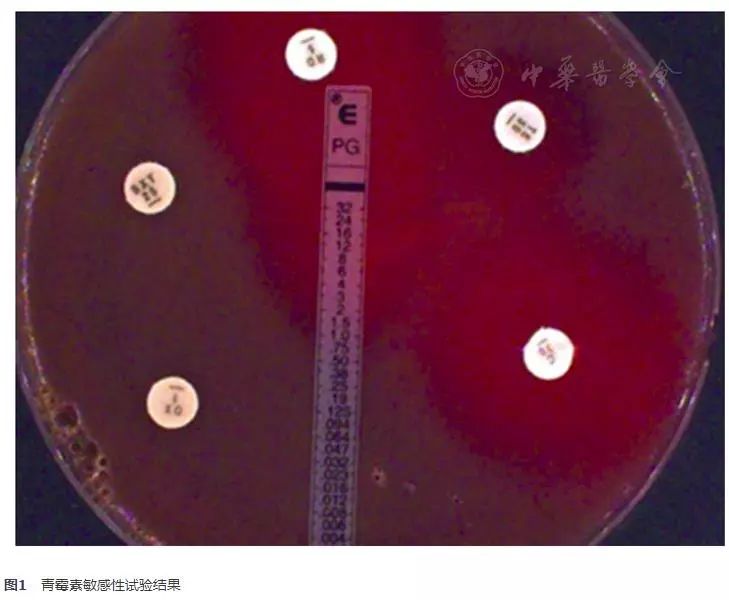
肺炎链球菌危险因素分析 (肺炎链球菌的耐药性分析)

本文原载于《国际呼吸杂志》2018年第20期
本文作者:刘刚 杨永清 魏莲花 邹凤梅 李可可

肺炎链球菌是革兰阳性双球菌,携带于正常人的鼻咽腔中,属于条件致病菌,当机体免疫力下降时可引起感染[1](尤其多见于呼吸道病毒感染后的婴幼儿、老年人及体弱多病者)。主要引起大叶性肺炎、胸膜炎、脓胸、也可引起中耳炎,乳突炎、副鼻窦炎、脑膜炎和败血症等[2]。随着抗菌药物的广泛应用,肺炎链球菌的耐药性逐渐严重,耐青霉素的肺炎链球菌的分离率也有逐年增高的趋势[3],及时掌握该菌的流行趋势及耐药特性对抗感染治疗具有重要意义。本文拟对2008~2015年我院临床标本肺炎链球菌分离率及其对常用抗菌药物的药敏试验结果进行调查分析,以了解肺炎链球菌感染和耐药性的变化趋势,为肺炎链球菌感染性疾病的诊断和治疗提供理论依据。
1 材料和方法
1.1 菌株来源
收集2008年1月至2015年12月我院临床(含门诊及住院部)送检呼吸道标本如痰、咽拭子、抽吸痰、肺泡灌洗液、纤维支气管镜洗液等共计39 080份,从收集的标本中分离肺炎链球菌,剔除同一患者相同部位分离的重复菌株,共计425株。
1.2 仪器和试剂
二氧化碳培养箱(美国Thermo Fisher公司)、痰消化液(英国Oxoid公司)、游标卡尺;药敏试验纸片:苯唑西林、利福平、左旋氧氟沙星、复方新诺明、克林霉素、红霉素、利奈唑胺、万古霉素、氯霉素、奎奴普丁/达福普汀、四环素等药敏纸片购于英国Oxoid公司;青霉素E-test购于生物梅里埃公司;根据2015版的临床微生物学检验标准化操作指导的配方配制哥伦比亚血琼脂平板、血MH培养基按照临床实验室标准化研究所(clinical laboratory standardization institute,CLSI)推荐的肺炎链球菌药敏培养基配方,所需的琼脂粉均购于Oxoid公司。
1.3 菌株分离与鉴定
参照《全国临床检验操作规程》(第三版)[4]中相关规定,痰标本需经过筛选、洗涤、涂片镜检、匀质化后接种血琼脂平板。其他标本可直接接种。置于35 ℃,5% CO2环境中培养24 h后,在原始涂片的指引下选择形态特点符合的菌落做触酶、革兰染色,并传代纯培养,贴奥普托欣纸片。生化反应做菊糖、蕈糖、棉子糖、山梨醇、甘露醇、七叶苷,糖发酵管加一滴小牛血清,浓厚接种;胆汁七叶苷、6.5% NaCl常量接种;胆汁溶菌试验采用试管法[4]。肺炎链球菌乳胶凝集与Lancefield抗原乳胶凝集按照试剂盒使用说明进行。将菌体形态与菌落形态符合、Optochin敏感、或者肺链链球菌乳胶凝集阳性的链球菌作为肺炎链球菌样细菌。
1.4 药敏试验
纸片扩散法(K-B法):挑取肺炎链球菌纯菌落,制成浊度为0.5麦氏标准管的菌悬液,用无菌棉拭子均匀涂布于5%去纤维羊血MHA平板,待平板表面水分稍干燥,贴上述药敏纸片,置于35 ℃、5% CO2环境孵育20~24 h,读取结果。
1.5 青霉素敏感性检测
若K-B法测得苯唑西林抑菌圈≤19 mm则用E-test法检测青霉素的最小抑菌浓度(minimum inhibitory concentration,MIC),药敏平板、菌悬液制备和涂布与K-B法相同,药敏纸片换成含有梯度浓度的青霉素E-test试剂条,同样置于35 ℃、5% CO2环境孵育20~24 h,读取结果。结果根据CLSI 2015年版判断标准进行判断。质控菌株为肺炎链球菌(ATCC 49619),购自卫生部临床检验中心。
2 结果
2.1 肺炎链球菌分离率
2008~2015年分离肺炎链球菌共425株,分离率为0.69%(标本总数61 024),年度分离率见表1。

2.2 肺炎链球菌科室分布
425株肺炎链球菌分布于不同临床科室中,科室分布前二位的分别为儿科和呼吸科,占59.7%(254/425)。肺炎链球菌感染多见于呼吸道病毒感染后的婴幼儿,所以儿科分离率居首,而呼吸科肺炎患者较多,分离率亦较多,见表2。

2.3 肺炎链球菌耐药性分析结果
根据CLSI药敏试验指南判断结果,肺炎链球菌对苯唑西林、利福平、左旋氧氟沙星、复方新诺明、克林霉素、红霉素、利奈唑胺、万古霉素、氯霉素、奎奴普丁/达福普汀、四环素的耐药性及其年度变化见表3。

2.4 青霉素敏感性检测
运用苯唑西林纸片法和E-test法对2010~2015年分离的425株肺炎链球菌进行青霉素敏感性试验检测。苯唑西林纸片法结果显示所有肺炎链球菌对青霉素均耐药,而E-test法结果却显示均敏感,两种方法测出的结果差异有统计学意义(图1)。
3 讨论
肺炎链球菌是引起呼吸道感染的常见分离菌且近年来的分离率有上升趋势,全国细菌耐药检测报告指出2015年全国范围内肺炎链球菌的分离率在革兰阳性菌中占9.3%,位于第四位[5]。本研究表明,2011年之前我院肺炎链球菌分离率均小于1.0%,这可能与抗生素的不合理使用、地理分布、培养技术的提高、菌落识别能力提高有很大的关系。然而,2013年以来肺炎链球菌的分离率相对于2012年有明显下降(分离数从2012年的129株至2013年的86株),这不仅与加强医院感染控制管理及抗菌药物的合理应用有关,更重要的是我们对肺炎链球菌的认识及防御措施有了提高。
肺炎链球菌的耐药机制复杂多样,因此对该菌的耐药性进行研究很有必要。本研究显示,8年间我院分离的肺炎链球菌对红霉素、克林霉素、复方新诺明的耐药率较高,这与其他地区及全国范围内的报道基本一致[5,6]。肺炎链球菌对奎奴普丁/达福普汀、四环素等抗菌药物的耐药率不高但却有逐年上升的趋势,此外,对利福平、左氧氟沙星以及利福平耐药率一直较低。对万古霉素、利奈唑胺这两种对革兰阳性菌抗菌作用较强的药物未发现耐药菌株。肺炎链球菌是呼吸道感染的重要病原菌,氨苄西林曾经是治疗肺炎链球菌感染的有效药物,然而随着抗菌药物的广泛使用,肺炎链球菌对氨苄西林的耐药性出现上升趋势[7]。
青霉素是治疗此类细菌感染的有效药物之一,按非脑膜炎(静脉)折点计算,2015年全国范围内青霉素耐药肺炎链球菌(penicillin-resistant Streptococcus pneumonia,PRSP)的检出率为4.2%[5]。2008~2015年我院未发现对青霉素耐药的肺炎链球菌,这可能与不断加强抗菌药物管理及医院感染控制管理有关。CLSI[8]推荐运用苯唑西林纸片法鉴定肺炎链球菌对青霉素的敏感性,抑菌环直径≥20 mm,提示肺炎链球菌对青霉素敏感;抑菌环直径≤19 mm,提示肺炎链球菌对青霉素可能耐药、敏感或中介,需用MIC方法进一步判断其耐药性。前期类似研究表明苯唑西林纸片法检测肺炎链球菌对青霉素的敏感性时敏感度较低,需用MIC法进一步检测[9]。本研究显示,苯唑西林检测肺炎链球菌对青霉素的敏感性时表现为全部耐药,显然对青霉素敏感的肺炎链球菌无法用苯唑西林纸片法检测出来,而当用MIC法检测时所有肺炎链球菌对青霉素均表现出敏感。此研究也进一步表明,当苯唑西林纸片法提示肺炎链球菌对青霉素耐药时,需进一步检测此菌对青霉素的MIC,而E-test法是检测肺炎链球菌青霉素MIC简单、结果稳定,最直观的方法。
为防止耐药性的进一步加剧,不仅需要临床医生合理使用抗菌药物,同时需要医护人员具有高度的责任心和无菌观念,所以必须加强对细菌耐药性和院内感染的教育和普及,降低和控制院内感染和抗生素滥用的现象。另一方面肺炎链球菌对复方磺胺甲噁唑、氨苄西林等多重耐药现象,提示实验室应加强对肺炎链球菌耐药的检测,同时指导临床对肺炎链球菌感染的经验用药应该谨慎。
(参考文献略)